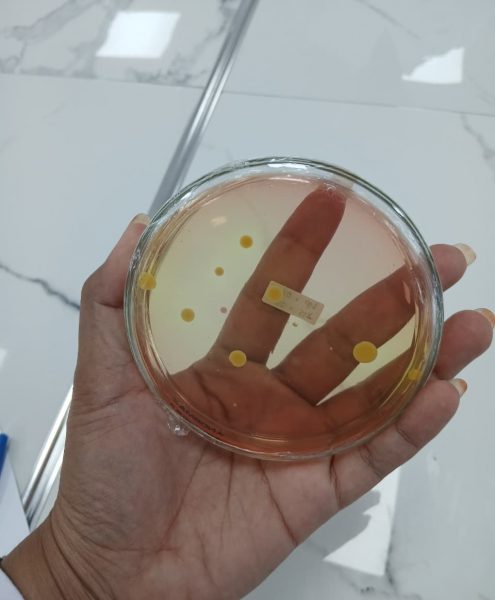

Teknologi Hasil Pertanian (THP) di Universitas Teuku Umar (UTU) adalah berfokus pada pengolahan, pengamanan, dan pengelolaan pascapanen untuk meningkatkan nilai tambah, menjaga mutu dan keamanan pangan, serta menciptakan produk inovatif yang berdaya saing di industri pangan dan pertanian. Prodi ini didirikan pada tanggal 3 Mei 2017 berdasarkan surat keputusan Menteri Riset, Teknologi dan Pendidikan tinggi nomor 240/KPT/I/2017 tentang izin pembukaan program studi Teknologi Hasil Pertanian Program Sarjana pada Universitas Teuku Umar. Prodi ini berada di bawah Fakultas Pertanian Universitas Teuku Umar dan sebagai Ketua Program Studi-nya periode 2025- 2029 adalah Lia Angraeni, SP., M.Sc
Program studi ini memiliki lima peminatan utama, yaitu:
-
Teknologi Pengolahan
-
Kimia dan Biokimia Hasil Pertanian
-
Mikrobiologi
-
Pascapanen
-
Teknologi Industri Pertanian
Lulusan THP memiliki peluang karier di berbagai bidang, mulai dari industri pangan, pertanian, hingga sektor terkait seperti keamanan pangan, kontrol kualitas, dan manajemen rantai pasokan. Program studi ini didukung oleh tenaga pengajar yang berkompeten dan berpengalaman, dengan komitmen menghadirkan kurikulum terpadu serta materi pembelajaran berkualitas. Tujuannya adalah membekali mahasiswa agar mampu menjadi individu yang terampil dan inovatif dalam bidang teknologi hasil pertanian. Setelah menyelesaikan studi, lulusan akan memperoleh gelar Sarjana Teknologi Pertanian (S.TP.) sebagai bentuk pengakuan atas kompetensi dan kualifikasi mereka di bidang Teknologi Pertanian, khususnya pada bidang pangan.